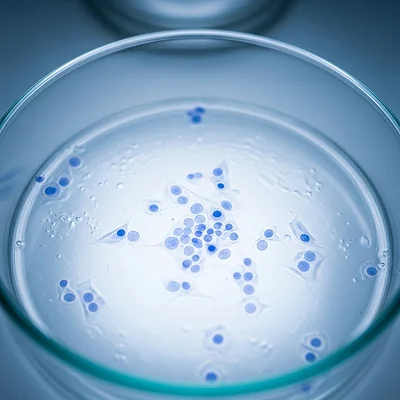
播種直後の培養容器内

細胞培養加工施設

ヒトの身体は
細胞から構築されています
再生医療では、その中でも特別な力を持つ「幹細胞」を利用し、傷ついた組織の修復を目指します。幹細胞を培養・加工する専門の施設を
CPC(CellProcessingCenter)と呼び、海外ではCPF(CellProcessingFacility)と表現されることもあります。
幹細胞治療において最も重要なのは、培養した細胞が「生きていること」です。死んだ細胞を投与しても効果は得られず、むしろ体に負担を与える可能性さえあります。そのため、生存率の高い細胞を確保すること、さらに体内で血管をスムーズに移動できるサイズを選定することが欠かせません。
脂肪由来の幹細胞培養は難易度が高いとされますが、当クリニックは国内でもトップレベルのCPCと提携。厳格な基準をクリアした環境で、患者さまに高品質な細胞をご提供しています。
CPCの主な設備について

クリーンルーム
細胞を清浄な環境で培養するための特別な部屋です。ほこりや微生物を徹底的に排除し、外部からの汚染を防ぐ構造になっています。この環境があることで、治療に用いる細胞の安全性と品質が守られています。

顕微鏡による観察
細胞の成長や変化を継続的にチェックするために使用。異常がないかを確認しながら、治療に適した状態へと育てていくのです。
細胞培養のプロセス
-
01

培養開始前
まずは環境を整え、細胞培養に入るための準備を行います。
-
02

幹細胞の抽出
脂肪組織から幹細胞を取り出す工程です。ここから治療がスタート。
-
03
播種直後
抽出した幹細胞を培養容器にまき、初期段階の様子を顕微鏡で観察します。
-
04

培養途中 Ⅰ
時間の経過とともに、細胞が伸びはじめ、少しずつ数を増やしていきます。
-
05

培養途中 Ⅱ
さらに増殖が進み、容器の中を覆うように拡張。ここで、患者さまの治療に用いるための「力強い細胞」が完成に近づいていきます。
access 診療時間・アクセス
診療案内
- 診療科目
- 美容皮膚科、美容形成、形成外科、再生医療
- 診療時間
- 10:00-13:00、14:00-19:00
(完全予約制) - 休診日
- 火曜日、木曜日、不定休
※最終受付時間は30分前になります。
| 診療科目 | 月 | 火 | 水 | 木 | 金 | 土 | 日 | 祝 |
|---|---|---|---|---|---|---|---|---|
| 10:00-13:00 | ○ | × | ○ | × | ○ | ○ | ○ | ○ |
| 14:00-19:00 | ○ | × | ○ | × | ○ | ○ | ○ | ○ |
担当医
| 担当医 | 月 | 火 | 水 | 木 | 金 | 土 | 日 |
|---|---|---|---|---|---|---|---|
| 新里 | 休診 | 吉井※ 石川 |
休診 | 新里 | 吉塚 | 朴※ 山田※ |
※不定期
アクセス
〒150-0002
東京都渋谷区渋谷1-23-18渋谷ワールドイーストビル10階
JR渋谷駅から徒歩4分














